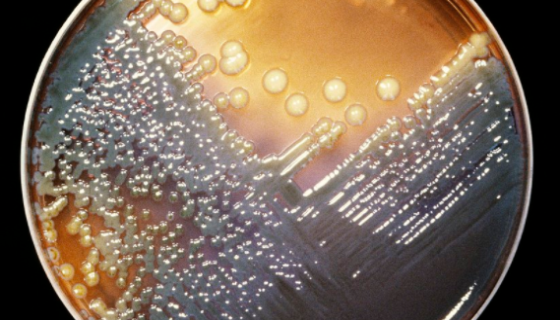
产气肠杆菌的性质、用途及生产工艺！
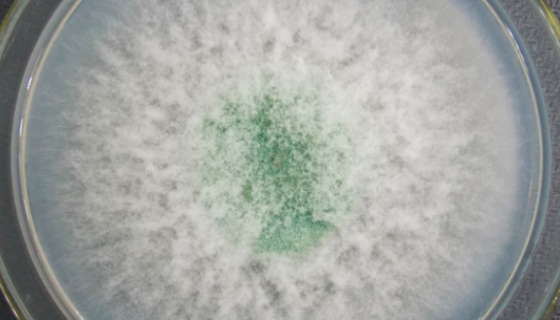
长枝木霉——用于生产纤维素霉曲和酶解粗饲料
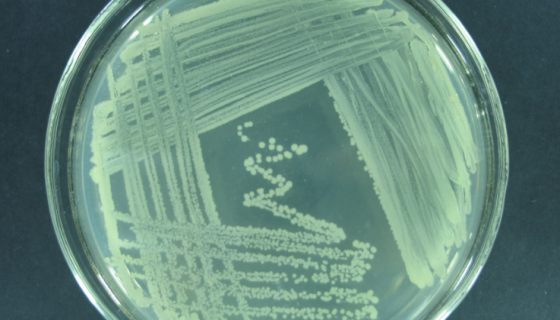
水雷夫松氏菌的培养方法与实验内容及使用范围！

大鼠肝枯否细胞的质量检测与培养操作方法!
大鼠枯否细胞分离自肝脏组织;肝脏是身体内以代谢功能为主的一个...

原代细胞人淋巴管内皮细胞的分离方法与质量检测!
人淋巴管内皮细胞分离自淋巴管组织;淋巴管由毛细淋巴管汇合而成...

水稻黑条矮缩病毒;稻黑条矮缩病毒 百欧ATCC菌种
水稻黑条矮缩病俗称矮稻,是由水稻黑条矮缩病毒引起、发生在水稻...
产气肠杆菌的性质、用途及生产工艺!
产气肠杆菌(Enterobacter aerogenes)系...
长枝木霉——用于生产纤维素霉曲和酶解粗饲料
长枝木霉,属于半知菌门,开始时为白色,致密,圆形,向四周扩展...

TRAMP-C2小鼠前列腺癌细胞的培养操作方法!
小鼠前列腺癌细胞分离自小鼠源前列腺癌的上皮细胞样贴壁细胞,主...
水雷夫松氏菌的培养方法与实验内容及使用范围!
水雷夫松氏菌,模式菌株,仅用于科学研究或者工业应用等非医疗目...

FLS人成纤维样滑膜细胞的处理方法与培养步骤!
人成纤维样滑膜细胞收到后的处理方法与培养步骤及注意事项有哪些...

蚜虫莫氏黑粉菌的菌株特点及培养与保存方法!
蚜虫莫氏黑粉菌,菌落粘稠,平伏,粉红色奶油状,光滑反光或有皱...